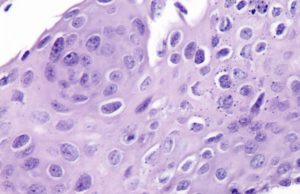

Angely Granados
Ya están abiertas las nominaciones para Tu Latino Destacado 2019
Las nominaciones para Tu
Latino Destacado 2019 ya están abiertas. La iniciativa creada por La Prensa
Canadá, busca destacar a aquellas personas que trabajan día a...
Un bebé nació en el estacionamiento de una tienda de comestibles...
El miércoles por la
mañana, el servicio de emergencia se dirigió a una tienda de comestibles de
Calgary para atender a una mujer estaba
en trabajo de...
Prisión de Alberta será el primer sitio de prevención de sobredosis...
A fines de junio, la Drumheller Institution de Alberta, una
prisión federal de seguridad media, se convertirá en la primera prisión del país en abrir...
Vibra el continente: La canción de Léo Santana y Karol G...
La Copa América Brasil 2019 ya tiene tema oficial, se trata
de la canción escrita por Rafinha RSQ, Léo Santana, Karol G y Ovy On...
Confirman un caso de difteria en una escuela primaria de Edmonton
A un estudiante de la escuela primaria de Edmonton se le ha
diagnosticado una infección rara y potencialmente mortal. Según reseña CBC News,
las autoridades sanitarias...
Un helicóptero se estrella contra un edificio en Nueva York
Un helicóptero se estrelló esta tarde en el techo de un
edificio de 54 pisos en Manhattan, Nueva York. Según informó el Departamento de
Bomberos (FDNY),...
¿Quieres hacer un máster en economía? BCE lanza programa de becas...
El Banco Central Europeo (BCE) anunció
el miércoles una beca de estudios solo para mujeres de escasos recursos para
que puedan cursar un máster de economía,...
OMS advierte que 1 millón de personas al día contraen infecciones...
Más de un millón de
personas en todo el mundo se contagian con una infección de transmisión sexual,
y las tasas de clamidia, gonorrea, tricomoniasis y...
La tasa de desempleo de Canadá cae a 5.4%, el nivel...
La economía canadiense agregó 27,700 empleos en mayo,
suficientes para reducir la tasa de
desempleo a 5.4 por ciento, su nivel más bajo desde 1976.
Statistics Canada...
China aumenta inspecciones a las importaciones de carne de cerdo canadiense
La agencia de aduanas de China planea aumentar las inspecciones de las importaciones de cerdo
canadiense y productos de cerdo, indicó Ottawa en un aviso...